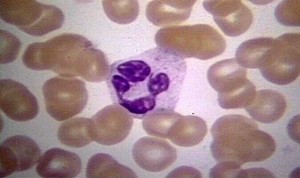
Причины повышения лейкоцитов Почему повышены лейкоциты в мазке
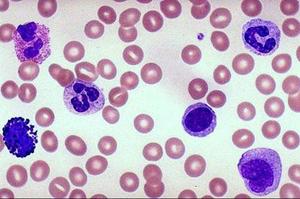
Лечение повышенного содержания лейкоцитов Анализ мозка на лейкоциты

Повышенные лейкоциты в мазке могут указывать на различные заболевания, требующие анализа и диагностики. В статье мы рассмотрим интерпретацию результатов анализов и нормы лейкоцитов у беременных. Особое внимание уделим клиническим проявлениям дисбактериоза, его причинам, методам диагностики и лечения. Понимание этих аспектов поможет женщинам своевременно выявить проблемы со здоровьем и обратиться за медицинской помощью.
Результаты анализов
Основным показателем, на который следует обратить внимание, является уровень лейкоцитов, который помогает оценить степень активности инфекционного процесса.
Лейкоциты
Нормальные значения лейкоцитов зависят от места, откуда был взят мазок: в уретре этот показатель колеблется в пределах 0-5-10, во влагалище — 0-10-15, а в цервикальном канале — 0-30. У женщин в положении допустимо увеличение лейкоцитов до 20 во влагалище. Высокий уровень лейкоцитов может указывать на венерические заболевания, острые воспаления придатков или кольпит.
При повышенных значениях лейкоцитов также важно учитывать дополнительные бактериостатические показатели: при молочнице наблюдается грибковая флора, при гонорее и бактериальном вагинозе — кокковые микроорганизмы, а при эндометрите увеличивается количество стафилококков. Бактерии, которые должны присутствовать в норме, а также уровень кислотности могут быть снижены. В норме мазок из влагалища не должен содержать гонококков, хламидий, трихомонад и грибов рода кандида.
Клетки плоского эпителия
Слизистая влагалища, а также мочеиспускательного и цервикального каналов покрыта плоским эпителием. В норме количество клеток плоского эпителия составляет 5-10. Если их нет в поле зрения, это может свидетельствовать об атрофии, а при повышенном уровне — о возможном воспалительном процессе.
Слизистая масса
Наличие умеренного количества слизистой массы в любом участке и её отсутствие в уретре считается нормальным.
Лактобациллы
В норме лактобактерии отсутствуют в уретре и цервикальном канале, но их количество должно быть достаточным во влагалище. Недостаток лактобацилл может указывать на риск бактериального вагиноза.
Дрожжи
Грибы рода кандида допустимы в небольшом количестве только во влагалище. Увеличение их числа может свидетельствовать о развитии молочницы.
Ключевые клетки
Это сочетание клеток гарднерелл и плоского эпителия. В здоровой микрофлоре их не должно быть. При их наличии ставится диагноз гарднереллёза с бактериальным вагинозом.
Лептотрикс
Это анаэробные бактерии, которые могут существовать без кислорода. Они могут присутствовать при различных инфекциях, таких как молочница в сочетании с бактериальным вагинозом, трихомоноз и хламидиоз.
Врачи отмечают, что повышенное количество лейкоцитов в мазке может служить важным индикатором различных заболеваний. Это состояние часто указывает на наличие воспалительного процесса в организме, что требует внимательного анализа. Специалисты подчеркивают, что для точной диагностики необходимо учитывать не только уровень лейкоцитов, но и другие показатели, такие как наличие патогенных микроорганизмов и характер выделений.
Врачи рекомендуют проводить комплексное обследование, включая дополнительные тесты и анализы, чтобы выявить первопричину повышения лейкоцитов. Это может быть связано с инфекциями, аллергическими реакциями или даже более серьезными заболеваниями. Важно, чтобы пациенты не игнорировали результаты анализов и обращались за консультацией к специалистам, которые помогут правильно интерпретировать данные и назначить соответствующее лечение.
https://youtube.com/watch?v=a1MEkB49kzU
Чистота влагалищной среды
Первая степень чистоты: лейкоциты 0-5
Это состояние считается оптимальным: в мазке наблюдается небольшое количество лейкоцитов, микрофлора в основном состоит из молочнокислых бактерий, а количество эпителиальных клеток минимально.
Вторая степень чистоты: лейкоциты 5-10
Эта степень относится к норме, однако могут присутствовать кокки или ограниченное количество дрожжевых грибов. Лактобактерии преобладают, лейкоциты находятся в умеренном количестве, а эпителий остается в пределах нормы.
Третья степень чистоты: лейкоциты от 10 до 50
Здесь наблюдается увеличение числа лейкоцитов, а также рост количества слизи и эпителия; количество лактобактерий уменьшается на фоне увеличения условно-патогенной флоры.
Четвёртая степень чистоты: лейкоциты превышают норму
В этом случае выявляются патогенные микроорганизмы (гонококки, трихомонады); лактобактерии отсутствуют, а количество слизи и эпителия значительно увеличивается из-за воспалительного процесса. Число лейкоцитов в мазке становится трудно поддающимся количественному определению. При выявлении двух последних степеней чистоты влагалища необходимо провести дополнительное обследование для определения причины воспаления и назначения соответствующего лечения.
| Причина повышенных лейкоцитов | Дополнительные симптомы | Диагностические методы |
|---|---|---|
| Инфекции (бактериальные, грибковые, вирусные) | Зуд, жжение, выделения (цвет, запах, консистенция), боль при мочеиспускании, дискомфорт внизу живота, лихорадка | Микроскопия мазка (окраска по Граму), посев на флору и чувствительность к антибиотикам, ПЦР-диагностика (на ИППП), ИФА (на вирусные инфекции) |
| Воспалительные процессы неинфекционного характера | Боль внизу живота, диспареуния (болезненный половой акт), нарушения менструального цикла, дискомфорт в области таза | УЗИ органов малого таза, кольпоскопия, биопсия (при подозрении на предраковые состояния или онкологию), определение онкомаркеров |
| Атрофический вагинит | Сухость, жжение, зуд во влагалище, диспареуния, частые позывы к мочеиспусканию, истончение слизистой | Осмотр гинеколога, определение pH влагалища, цитологическое исследование мазка, гормональный профиль |
| Аллергические реакции | Зуд, покраснение, отек наружных половых органов, контактный дерматит | Сбор анамнеза (контакт с аллергенами), исключение аллергена, кожные пробы |
| Травмы или раздражение слизистой | Боль, дискомфорт, кровотечение (при травме), покраснение | Осмотр гинеколога, сбор анамнеза (использование тампонов, спринцевание, половой акт) |
| Наличие инородного тела | Боль, выделения, неприятный запах, дискомфорт | Осмотр гинеколога, УЗИ органов малого таза |
| Онкологические заболевания | Неспецифические симптомы (кровотечения, боли, выделения), потеря веса, слабость | Кольпоскопия, биопсия, цитологическое исследование мазка (ПАП-тест), УЗИ, КТ/МРТ |
| Физиологические состояния (например, овуляция, беременность) | Отсутствие других патологических симптомов, связь с фазой цикла или беременностью | Повторный мазок после менструации или родов, исключение других причин |
Повышение лейкоцитов
При заболеваниях:
- воспаление придатков (аднексит);
- воспаление матки (эндометрит);
- воспаление мочевыводящих путей (уретрит);
- воспаление шейки матки (цервицит);
- воспаление влагалища (кольпит);
- урогенитальный микоплазмоз;
- туберкулез половых органов (палочка Коха);
- паховая гранулема (тельца Донована);
- опухолевые образования;
- ЗППП — венерические инфекции, такие как сифилис, гонорея, трихомониаз, хламидиоз;
- ВИЧ;
- дисбактериоз влагалищной или кишечной микрофлоры;
- заболевания органов системы;
- генитальный герпес;
- амебы;
- вирус иммунодефицита;
- папилломавирус;
- цитомегаловирус;
- кандидоз (молочница);
- грибы актиномицеты;
- нарушения гормонального баланса;
- онкологические заболевания половых органов.
Физиологические причины:
- беременность;
- предменструальный синдром;
- причины, не связанные с инфекциями, передающимися половым путем.
Увеличение уровня лейкоцитов может быть связано с хроническим переутомлением, стрессом, длительным курсом антибиотиков или применением других медикаментов.
Беременность: нормы лейкоцитов
В мазке у беременной женщины нормальный уровень лейкоцитов составляет от 15 до 20 клеток в поле зрения. В течение беременности анализ мазка необходимо проводить как минимум три раза. В период роста плода повышенное количество лейкоцитов в мазке является естественным следствием гормональных изменений в организме женщины. Уровень прогестерона и эстрогенов возрастает, а количество лактобактерий увеличивается, что способствует росту лейкоцитов и подавляет условно-патогенные микроорганизмы. При ослаблении иммунной системы беременной влагалищная среда становится более уязвимой к инфекциям, что приводит к активации лейкоцитов.
https://youtube.com/watch?v=12qT3ghiOY0
Предпосылки дисбактериоза
Воспалительные процессы развиваются на фоне условно-патогенной микрофлоры, включая бактерии кишечной палочки, грибки, стрептококки, стафилококки и гарднереллы.
Дисбактериоз: основные причины
- Изменения в гормональной системе женщины, которые могут возникнуть во время беременности, климакса, выкидыша или при эндокринных заболеваниях.
- Снижение защитных функций во влагалищной среде.
- Психоэмоциональное переутомление и стресс.
- Практика орального секса.
- Проведение лучевой или химической терапии.
- Изменения в структуре влагалища, вызванные хирургическими вмешательствами, родами, абортами или анатомическими особенностями.
- Наличие инородных тел во влагалище, включая средства личной гигиены.
- Использование контрацептивов, таких как спермициды в различных формах.
- Частая смена половых партнёров.
Дисбактериоз: аллергические реакции
- Аллергия на лубриканты и интимные смазки.
- Реакция на вагинальные препараты или спринцевания.
- В редких случаях — аллергия на сперму партнёра.
Дисбактериоз: раздражение слизистой влагалища
- Недостаточная интимная гигиена.
- Температурные колебания, такие как переохлаждение или перегрев.
- Дискомфорт от ношения нижнего белья.
- Воздействие химических веществ.
- Соматические заболевания, включая диабет, нарушения работы мочеполовой системы, гепатит и почечную недостаточность.
Клинические проявления
- Частое и болезненное мочеиспускание может указывать на цистит или уретрит.
- Ложные ощущения переполненности кишечника могут свидетельствовать о кишечном дисбактериозе.
- Выделения с резким запахом могут быть признаком вагинита, цервицита или воспалительного процесса.
- Пенные или гнойные выделения могут указывать на молочницу, гонорею или трихомоноз.
- Болезненные ощущения во время половой активности могут быть связаны с нарушениями в структуре шейки матки или придатков.
- Сбои в менструальном цикле при повышенном уровне лейкоцитов могут указывать на воспаление придатков.
Диагностика дисбактериоза
При обнаружении повышенного уровня лейкоцитов в мазке важно выяснить причины этого состояния. Для этого проводят различные исследования, включая ПЦР-диагностику, анализ ДНК для определения возбудителя, бактериологический посев, мазки на скрытые инфекции и цитологическое исследование, а также биопсию и анализ антител. В зависимости от ситуации могут быть назначены и другие методы диагностики.
Мазок из канала матки
Анализ мазка позволяет выявить возбудителя инфекции и оценить его чувствительность к антибиотикам, что помогает в назначении адекватного лечения.
ПЦР на скрытую инфекцию
Этот метод диагностики позволяет точно установить причину инфекционного процесса, который может протекать бессимптомно и угрожать бесплодием у женщины.
УЗИ придатков
Рекомендуется проводить ультразвуковое исследование с использованием трансвагинального датчика. Повышенные лейкоциты могут быть следствием воспалительных процессов в придатках матки, но также могут указывать на наличие опухолевых образований, таких как кисты, саркомы, миомы или полипы.
Кольпоскопия
Использование кольпоскопа с увеличением позволяет детально осмотреть слизистую и выявить патологии, которые могут быть не видны при стандартном обследовании. К таким проблемам относятся онкологические заболевания, лейкоплакия и дисплазия шейки матки. Повышенное количество лейкоцитов в мазке может свидетельствовать о наличии острых патологий, а также о скрытых инфекциях. В таких случаях назначаются местные препараты, а при необходимости — противовирусные, антипаразитарные и антибиотики. Проводится комплексное лечение, направленное на восстановление местной микрофлоры и борьбу с гинекологическими и соматическими заболеваниями.
Лечение
Местное лечение
- продолжительность курса составляет до 5 дней;
- используются антисептические растворы, такие как перманганат калия, мирамистин и хлоргексидин;
- спринцевание производится отварами трав, включая ромашку, зверобой, календулу и мать-и-мачеху;
- лечение с помощью свечей продолжается около 14 дней (гексион, полижинакс, бетадин);
- при урогенитальном кандидозе рекомендуется использовать противогрибковые свечи (клотримазол, ливарол, пимафуцин).
Лечение скрытых инфекций
В случае вирусной инфекции или венерического заболевания необходимо применять комплексное лечение, включающее антибиотики и противовирусные препараты. Выбор медикаментов осуществляется с учетом особенностей воспалительного процесса.
Восстановление микрофлоры
На завершающем этапе важно восстановить уровень молочнокислых бактерий. В этом помогут свечи с пробиотиками: Лактобактерин, Лактожиналь, Ацилакт, Колибактерин, Вагилак и Бифидумбактерин. Курс лечения может длиться от 2 до 4 недель.
Консультации смежных специалистов
Для глубокого понимания причин, приведших к болезненному состоянию, важно учитывать результаты проведённых обследований. Специалисты, анализирующие схожие симптомы в контексте других заболеваний, смогут предложить полезные рекомендации.
Эндокринолог сосредоточится на исключении сахарного диабета и нарушений в работе щитовидной железы, а также при необходимости назначит соответствующее лечение. Нефролог проведёт обследование на наличие пиелонефрита или цистита и, если потребуется, назначит антибиотики для борьбы с воспалением. Аллерголог посоветует обратить внимание на возможные раздражающие факторы, такие как материалы нижнего белья, средства личной гигиены или принимаемые медикаменты. Невролог может рекомендовать успокоительные средства на основе натуральных трав при нервных расстройствах, которые могут способствовать увеличению уровня лейкоцитов в организме.
https://youtube.com/watch?v=8nc8_w2EIZM
Симптомы заболеваний, связанных с повышением лейкоцитов
Повышение уровня лейкоцитов в мазке может быть признаком различных заболеваний, и его интерпретация требует внимательного анализа сопутствующих симптомов. Лейкоциты, или белые кровяные клетки, играют ключевую роль в иммунной системе, защищая организм от инфекций и воспалений. Когда их уровень повышен, это может указывать на наличие воспалительного процесса, инфекции или даже более серьезных заболеваний.
Одним из наиболее распространенных симптомов, связанных с повышением лейкоцитов, является лихорадка. Повышение температуры тела может свидетельствовать о том, что организм борется с инфекцией. В зависимости от типа инфекции, лихорадка может быть постоянной или периодической, а также сопровождаться ознобом и потоотделением.
Другим важным симптомом является боль. Она может проявляться в различных областях тела в зависимости от локализации воспалительного процесса. Например, при инфекциях мочевыводящих путей пациенты могут испытывать дискомфорт или резь в области живота или поясницы, а при пневмонии — боль в груди, усиливающуюся при дыхании или кашле.
Кроме того, повышенные лейкоциты могут быть связаны с такими симптомами, как усталость, слабость и общее недомогание. Эти проявления часто возникают из-за того, что организм тратит много энергии на борьбу с инфекцией или воспалением. У некоторых пациентов может наблюдаться потеря аппетита и снижение массы тела, что также указывает на наличие заболевания.
Кожные проявления, такие как сыпь, покраснение или отек, могут также указывать на воспалительные процессы, связанные с повышением уровня лейкоцитов. Например, при аллергических реакциях или инфекциях кожи наблюдаются характерные изменения, которые могут быть диагностированы с помощью мазка.
Важно отметить, что симптомы могут варьироваться в зависимости от конкретного заболевания. Например, при хронических воспалительных заболеваниях, таких как артрит, пациенты могут испытывать постоянные боли в суставах, отеки и ограничение подвижности. В таких случаях повышенные лейкоциты могут быть одним из показателей активности заболевания.
Таким образом, диагностика заболеваний на фоне повышенных лейкоцитов требует комплексного подхода, включающего анализ клинических симптомов, лабораторных данных и, при необходимости, инструментальных исследований. Правильная интерпретация этих данных позволяет врачу установить точный диагноз и назначить адекватное лечение.
Методы лабораторной диагностики
Лабораторная диагностика заболеваний, сопровождающихся повышением уровня лейкоцитов в мазке, включает в себя несколько ключевых методов, позволяющих установить точный диагноз и определить причину воспалительного процесса. Основными методами являются общий анализ крови, микроскопия мазков, бактериологические исследования и молекулярно-генетические тесты.
Общий анализ крови является первым шагом в диагностике. Он позволяет оценить уровень лейкоцитов, а также их дифференциацию. Увеличение общего числа лейкоцитов (лейкоцитоз) может свидетельствовать о наличии инфекции, воспаления, аллергической реакции или даже онкологических заболеваний. Важно также обратить внимание на соотношение различных типов лейкоцитов: нейтрофилов, лимфоцитов, моноцитов, эозинофилов и базофилов, так как это может дать дополнительную информацию о характере заболевания.
Микроскопия мазков позволяет более детально изучить морфологию клеток. При этом исследуется не только количество лейкоцитов, но и их состояние. Например, наличие атипичных клеток может указывать на злокачественные процессы, тогда как преобладание нейтрофилов может свидетельствовать о бактериальной инфекции. Мазки могут быть взяты из различных биологических материалов, таких как кровь, моча, слизь или экссудат, в зависимости от предполагаемого заболевания.
Бактериологические исследования проводятся для выявления патогенных микроорганизмов. Они включают посев образцов на питательные среды, что позволяет определить наличие бактерий, их количество и чувствительность к антибиотикам. Это особенно важно при инфекционных заболеваниях, так как правильный выбор антибиотикотерапии зависит от результатов этих исследований.
Молекулярно-генетические тесты становятся все более популярными в диагностике инфекционных заболеваний. Эти методы позволяют выявлять ДНК или РНК патогенов, что обеспечивает высокую чувствительность и специфичность диагностики. Например, ПЦР (полимеразная цепная реакция) может обнаруживать даже небольшие количества вирусной или бактериальной ДНК, что особенно важно в случаях, когда традиционные методы не дают результатов.
Таким образом, комплексный подход к лабораторной диагностике, включающий в себя различные методы, позволяет не только подтвердить наличие лейкоцитоза, но и установить его причину, что является ключевым для выбора правильной тактики лечения.
Профилактика заболеваний, приводящих к повышению лейкоцитов
Профилактика заболеваний, приводящих к повышению лейкоцитов, является важной задачей как для медицинских работников, так и для пациентов. Высокий уровень лейкоцитов в мазке может свидетельствовать о наличии воспалительных процессов, инфекций или других патологий. Поэтому понимание методов профилактики может помочь снизить риск развития заболеваний и улучшить общее состояние здоровья.
Одним из ключевых аспектов профилактики является поддержание здорового образа жизни. Это включает в себя сбалансированное питание, регулярные физические нагрузки и достаточный уровень сна. Правильное питание, богатое витаминами и минералами, способствует укреплению иммунной системы, что, в свою очередь, помогает организму бороться с инфекциями и воспалениями. Рекомендуется включать в рацион свежие фрукты и овощи, цельнозерновые продукты, нежирные белки и полезные жиры.
Регулярные физические нагрузки также играют важную роль в профилактике заболеваний. Умеренная физическая активность способствует улучшению кровообращения, укреплению сердечно-сосудистой системы и повышению общего уровня энергии. Рекомендуется заниматься физической активностью не менее 150 минут в неделю, что может включать в себя прогулки, плавание, йогу или другие виды спорта.
Кроме того, важно уделять внимание гигиене и профилактике инфекционных заболеваний. Соблюдение правил личной гигиены, таких как регулярное мытье рук, использование антисептиков и избегание контакта с больными людьми, может значительно снизить риск заражения. Вакцинация также является важным элементом профилактики, так как она помогает защитить организм от различных инфекций, которые могут привести к повышению уровня лейкоцитов.
Не менее важным аспектом является регулярное медицинское обследование. Профилактические осмотры и анализы позволяют выявить заболевания на ранних стадиях, что значительно увеличивает шансы на успешное лечение. При наличии хронических заболеваний, таких как диабет или заболевания сердца, необходимо строго следовать рекомендациям врача и регулярно контролировать свое состояние.
Также стоит обратить внимание на психоэмоциональное состояние. Стресс и эмоциональное напряжение могут негативно сказаться на иммунной системе, что может привести к повышению уровня лейкоцитов. Практики релаксации, такие как медитация, дыхательные упражнения и занятия хобби, могут помочь снизить уровень стресса и улучшить общее самочувствие.
В заключение, профилактика заболеваний, приводящих к повышению лейкоцитов, требует комплексного подхода, включающего здоровый образ жизни, соблюдение гигиенических норм, регулярные медицинские обследования и управление стрессом. Следуя этим рекомендациям, можно значительно снизить риск развития заболеваний и поддерживать здоровье на высоком уровне.